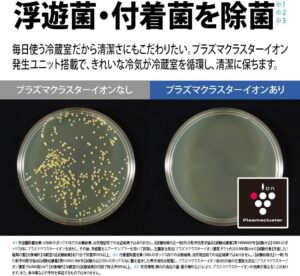

シャープ SJ-X502P-S 冷蔵庫 幅68.5cm 502L ピラーレスフレンチドア
シャープ SJ‑X502P‑S は、幅68.5cmで設置しやすい 502L の大容量フレンチドア冷蔵庫。中央の柱がない ピラーレス構造で大きな食材も出し入れしやすく、庫内が見渡しやすいのが特徴です。プラズマクラスターで庫内の清潔を保ち、節電モードや自動節電機能も搭載。使いやすさと省エネ性を両立したファミリー向けモデルです。
シャープ SJ‑X502P‑Sを見たい方は、下記をクリックしてください。
シャープ SJ-X502P-S 冷蔵庫 幅68.5cm 502L ピラーレスフレンチドアの機能や特徴
シャープ SJ‑X502P‑S は、ピラーレスフレンチドア(観音開き)

SJ‑X502P‑S の最大の特徴は、中央の柱(ピラー)がないフレンチドア構造です。
一般的なフレンチドア冷蔵庫は、左右の扉の間に柱があり、開閉時にどうしても視界や出し入れの邪魔になります。しかし、このモデルはピラーレス構造を採用しているため、扉を開けた瞬間に庫内がワイドに開け、見渡しやすく、出し入れが非常にスムーズです。
特に、大きな鍋、パーティー料理、ケーキの箱、幅のある食材などを扱う家庭では、ピラーレスの恩恵が大きく、ストレスなく収納できます。また、庫内の見通しが良いため、食材の“見落とし”が減り、食品ロスの削減にもつながります。
シャープ SJ‑X502P‑Sを見たい方は、下記をクリックしてください。
シャープ SJ‑X502P‑S は、502L の大容量(冷蔵室・冷凍室・野菜室のバランスが良い)
502L という容量は、4〜5人以上のファミリー層に十分対応できるサイズです。
冷蔵室・冷凍室・野菜室のバランスが良く、まとめ買いをする家庭でも余裕があります。
冷蔵室は広く、棚の高さ調整も柔軟
冷凍室は大容量で、作り置きや冷凍食品のストックに強い
野菜室は深さがあり、葉物から根菜まで収納しやすい
また、幅68.5cmという“日本の住宅事情に合わせたサイズ”でありながら、502Lの大容量を実現している点も魅力です。キッチンのスペースが限られていても設置しやすいのが強みです。
シャープ SJ‑X502P‑Sを見たい方は、下記をクリックしてください。
シャープ SJ‑X502P‑S は、プラズマクラスターで庫内を清潔に保つ
シャープ独自の「プラズマクラスター」を搭載しており、庫内の空気を清潔に保つ効果があります。
プラズマクラスターは、浮遊菌や付着菌の抑制、ニオイの軽減に役立ち、庫内の衛生環境を整えることで、食材の鮮度保持にも貢献します。
特に、冷蔵庫内はニオイが混ざりやすい環境ですが、プラズマクラスターが働くことで、肉や魚のニオイ、野菜の湿気によるこもり臭などを抑え、快適な庫内環境を維持できます。
シャープ SJ‑X502P‑Sを見たい方は、下記をクリックしてください。
シャープ SJ‑X502P‑S は、使いやすい収納設計(見やすい・取り出しやすい)
SJ‑X502P‑S は、ユーザーの使いやすさを重視した収納設計が特徴です。
■ 冷蔵室
LED照明で庫内が明るく、奥まで見やすい
高さ調整できるガラス棚
ドアポケットは大容量で、2Lペットボトルも余裕
ピラーレスでワイドに開くため、全体が見渡しやすい
■ 野菜室
深型で、立てて収納しやすい
仕切りが使いやすく、整理が簡単
■ 冷凍室
大容量で、上段・下段に分かれて整理しやすい
冷凍食品のまとめ買いに強い
作り置きや小分け保存にも便利
全体的に、“どこに何があるか一目で分かる”という使いやすさが際立っています。
シャープ SJ‑X502P‑Sを見たい方は、下記をクリックしてください。
シャープ SJ-X502P-S 冷蔵庫 幅68.5cm 502L ピラーレスフレンチドアのまとめ
シャープ SJ‑X502P‑S は、幅68.5cmで設置しやすい 502L の大容量フレンチドア冷蔵庫。中央の柱がない ピラーレス構造により、庫内が広く見渡せ、大きな鍋やパーティー料理もスムーズに出し入れできます。プラズマクラスターで庫内の清潔を保ち、食材の鮮度維持にも貢献。節電モードや自動節電機能を備え、省エネ性能も優秀です。使いやすいレイアウトと高い収納力を両立し、家族のまとめ買いにも対応できる実用性の高いモデルです。
シャープ SJ‑X502P‑Sを見たい方は、下記をクリックしてください。


コメント